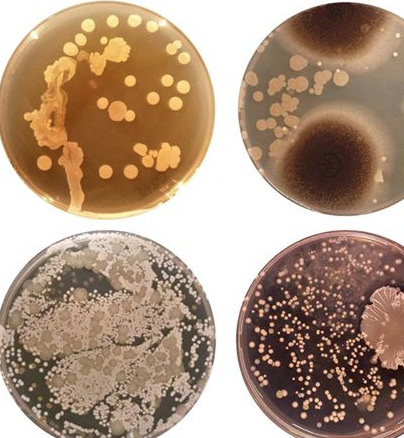

Göbeğinizde 'sadece Japonya'da yaşayan' bir bakteri olabilir
Rob Dunn adlı bir bilim adamının göbekte biriken bakterilerle ilgili yaptığı çalışmalarda inanılmaz bulgulara rastlandı.
Rob Dunn adlı bilim adamı, 60 denekle gerçekleştirdiği bir deneyde, göbek deliklerinden aldığı numuneler üzerinde inanılmaz bakteriler keşfetti.
National Geographic'in haberine göre, numunelerde 2368 çeşit bakteriye rastlandı ve bunların neredeyse 1458 tanesi daha önce bilinmeyen bakteriler.
JAPONYA'YA HİÇ GİTMEMİŞ AMA...
Dunn'un bir denekten aldığı örnekte bulunan bakteri daha önce sadece Japonya'da bir çeşit toprakta görülmüş. Fakat garip olan, bu deneğin daha önce hiç Japonya'ya gitmemiş olması.
BİRKAÇ SENEDİR YIKANMAYAN DENEKTE...
Birkaç senedir yıkanmayan bir denekteki bakteriye ise kutuplardaki buz tabakalarında ve okyanusların derinliklerinde bulunan hidrotermal bacalarda rastlanıyor. Bu bakterilere 'ekstremofil' deniyor. Ekstremofiller çoğunlukla tek hücreli olup ekstrem koşullarda yaşama gereksinim duyan ve bu koşullarda optimum olarak gelişen organizmalara deniyor.